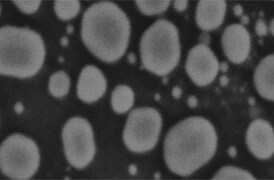
scanning-electron-microscope-manufacturers-274x180 scanning-electron-microscope-manufacturers-274x180

Search
Search

Scanning electron microscopes (SEMs) are highly versatile tools and used across a number of industrial, commercial and research applications. With nanoscale and even sub-nanoscale resolutions available, SEMs can provide you with extensive information on a sample’s topography, morphology and chemical composition. SEMs are indispensable tools and today’s machines are now faster, easier to use and increasingly used across a broad range of applications.
SEMs are powerful analysis machines that combine high throughput levels with guaranteed data quality to accelerate your time to results.
There are many scanning electron microscope advantages. An SEM is capable of high depths of field and high resolutions, allowing you to zoom into defects and faults and examine them with a high level of detail.
You can gain comprehensive information on a sample’s topography, morphology and chemical composition, using tools including Energy Dispersive Spectroscopy (EDS) microanalysis. These capabilities are often available with the click of a button thanks to advancing automation and innovations such as our ChemiSEM Technology.
The automotive manufacturing industry must now comply with two strict cleanliness standards for its fluid systems – VDA19 and ISO16232.
Both ISO 16232 and VDA 19 are integral parts of today’s quality management landscape. Simply put, if a manufacturer wants their part in a commercial vehicle, it must pass ISO 16232.
A scanning electron microscope (SEM) can simplify your cleanliness analysis workflows, reduce your time to results and provide you with a greater level of detail to analyze your results and pass your compliance tests with ease.
Scanning electron microscopes are versatile and superior instruments for quality assurance and quality control.
Today’s SEMs reveal an unimaginable level of detail, helping you to analyze the morphology, topography and chemical composition of your samples with ease. With the addition of energy-dispersive X-ray spectroscopy (EDS), you can simultaneously determine the morphology and elemental composition of different materials – and with the click of a button thanks to our exclusive ChemiSEM Technology.
In short, an SEM is a key tool to identify different materials with ease, providing a level of detail and information, revealing defects and imperfections that may otherwise be missed.
Automated quality control allows you to set specific test criteria and uses real-time tracking to monitor your quality control processes. When these processes are complete, a report is then automatically produced, detailing the results and measurements taken.
Modern SEMs also use automation across a range of tools and techniques, to conduct repetitive and time-consuming tasks. This not only accelerates your time to results but also improves your data quality.
This is because automated quality control processes are accurate and repeatable. They provide consistency and repeatability of your measurements where your sample mounting and other parameters are automated. What’s more, using tools like our ChemiSEM Technology, you can get comprehensive elemental information with the click of a button.
Today’s SEMs are superior quality control and failure analysis machines. They provide high SEM resolutions and comprehensive information, helping you to analyze the morphology, topography and chemical composition of your samples with ease.
When deciding on your SEM, it’s important to take a range of factors into consideration. With increasing resolution, for example, your costs and instrument footprint also increases. Your SEM sample types are another key consideration, where you must select the right tool for the job.
A scanning electron microscope (SEMs) is a long-term investment for any laboratory. It’s important to choose the right manufacturer to help you get the most out of your instruments.
When comparing scanning electron microscope manufacturers, you should assess the quality of their machines, areas of expertise and the level of support they can provide to your laboratory.
At Thermo Fisher Scientific, we have a range of analytical SEMs and can advise you on the best option to meet the specific needs of your laboratory. We provide our customers with extensive support, helping you accelerate your time to results and futureproof your analytical capabilities.